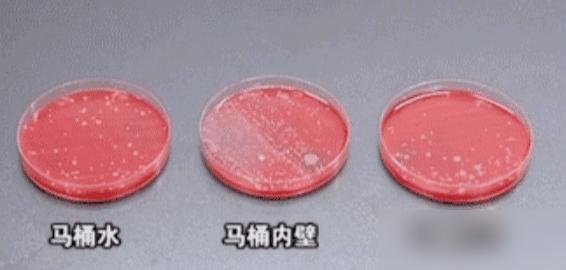

谁家里没为厕所门犯过愁?最近刷到好多人说,厕所门不能正对入户门、卧室、厨房,这可不是老一辈的“迷信”!你想啊,一开门就见厕所,客人来了多尴尬;卧室是睡觉的地方,细菌飘进去,深度睡眠时免疫力弱,能不闹毛病吗?厨房做吃的,厕所异味细菌飘过去,食物污染了吃进肚子里,能健康吗?我觉得这就是生活的“小讲究”,咱中国人图的不就是“家宅安稳”嘛?你们家厕所门对着啥?有没有踩过这些雷?赶紧去看看,改了才踏实!


谁家里没为厕所门犯过愁?最近刷到好多人说,厕所门不能正对入户门、卧室、厨房,这可不是老一辈的“迷信”!你想啊,一开门就见厕所,客人来了多尴尬;卧室是睡觉的地方,细菌飘进去,深度睡眠时免疫力弱,能不闹毛病吗?厨房做吃的,厕所异味细菌飘过去,食物污染了吃进肚子里,能健康吗?我觉得这就是生活的“小讲究”,咱中国人图的不就是“家宅安稳”嘛?你们家厕所门对着啥?有没有踩过这些雷?赶紧去看看,改了才踏实!